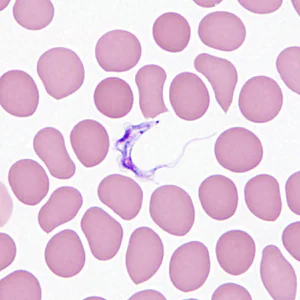
Case362_C.jpg

Case #362 – December 2013
A 29-year-old female post-graduate student in Zoology went on an expedition to see the lowland gorillas in the Democratic Republic of Congo. She reported numerous insect bites while traveling but did take anti-malarial prophylaxis. Approximately one week after returning home she developed fever. About a month later, she started experiencing headaches, itchy skin, and swollen lymph nodes and sought medical attention. A blood specimen was collected; smears made and stained with Wright-Giemsa. The objects shown in Figures A–D were observed in moderate numbers. What is your diagnosis? Based on what criteria?

Figure A

Figure B
Figure C

Figure D
Images presented in the DPDx case studies are from specimens submitted for diagnosis or archiving. On rare occasions, clinical histories given may be partly fictitious.
DPDx is an educational resource designed for health professionals and laboratory scientists. For an overview including prevention, control, and treatment visit www.cdc.gov/parasites/.
